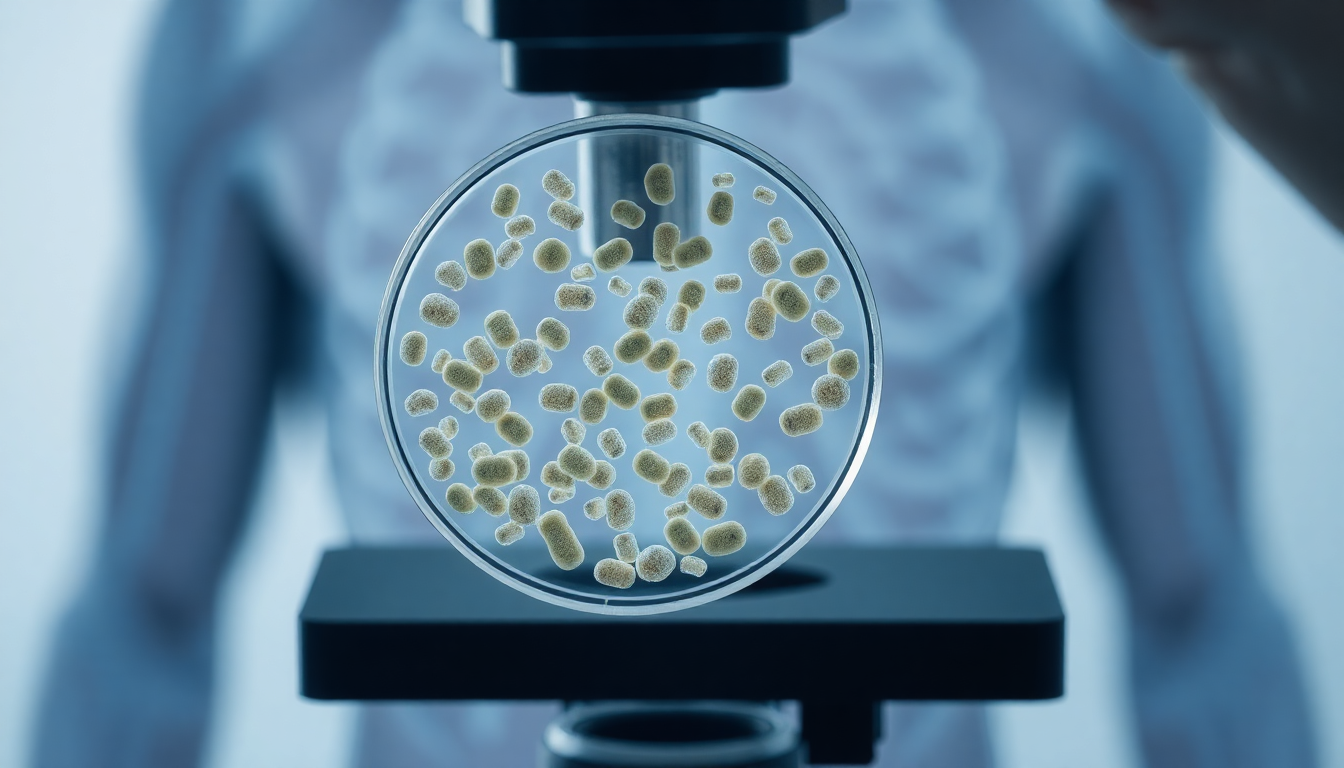
Conclusion

E. coli Bacteria: An Overview
📑 5 slides
👁 73 views
📅 2/13/2026
Introduction to E. coli
E. coli is a type of gram-negative bacteria

2
Characteristics of E. coli
- Rod-shaped, 2-4 μm in length
- Has a cell wall and outer membrane
- Can grow in a variety of temperatures and environments

3
Habitats and Transmission
- Found in soil, water, and food, especially meat and dairy products
- Can contaminate food through fecal matter
- Person-to-person transmission is rare

4
Importance and Applications
- Used in biotechnology for protein production and vaccine development
- Helps in digestion and production of vitamins in the gut
- Model organism for scientific research

5
Conclusion
- E. coli is a complex and important bacterium
- Understanding its characteristics and habitats is crucial
- Further research can lead to new applications and treatments
1 / 5